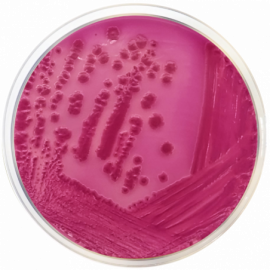

Violet Red Bile Agar with Lactose (VRBL) ISO
Selective medium for the detection and enumeration of coliforms in dairy products, water and food.
Principles and uses
Violet Red Bile Agar with Lacose (VRBL), containing Bile and Violet Red dye, is based on MacConkey Agar for the detection and
enumeration of lactose-fermenting bacteria and the differentiation of coliforms or Coliaerogenes group from non-lactose fermenting organisms in dairy products, water and foods.
Peptone provides nitrogen, vitamins, minerals and amino acids essential for growth. Yeast extract is a source of vitamins, particularly of the B-group. Lactose is the fermentable carbohydrate providing carbon and energy. Bile salts and crystal violet inhibit Gram-positive bacteria. Neutral red is a pH indicator. Sodium chloride supplies essential electrolytes for transport and osmotic balance. Bacteriological agar is the solidifying agent. It is convenient to use the pour plate method.
Lactose fermenters form red colonies with red-purple halos. Occasionally the cocci of the intestinal tract can develop as small, punctiform red colonies. The purplish red colonies with a diameter of at least (sometimes surrounded by a reddish zone of precipitated bile) are considered as typical colonies of coliforms and do not require further confirmation.
Atypical colonies (e.g. of smaller size), and all colonies derived from milk products that contain sugars other than lactose, may result in colonies with an appearance that looks similar to the typical coliforms. These colonies should be confirmed in tubes of Brilliant Green Bile Broth